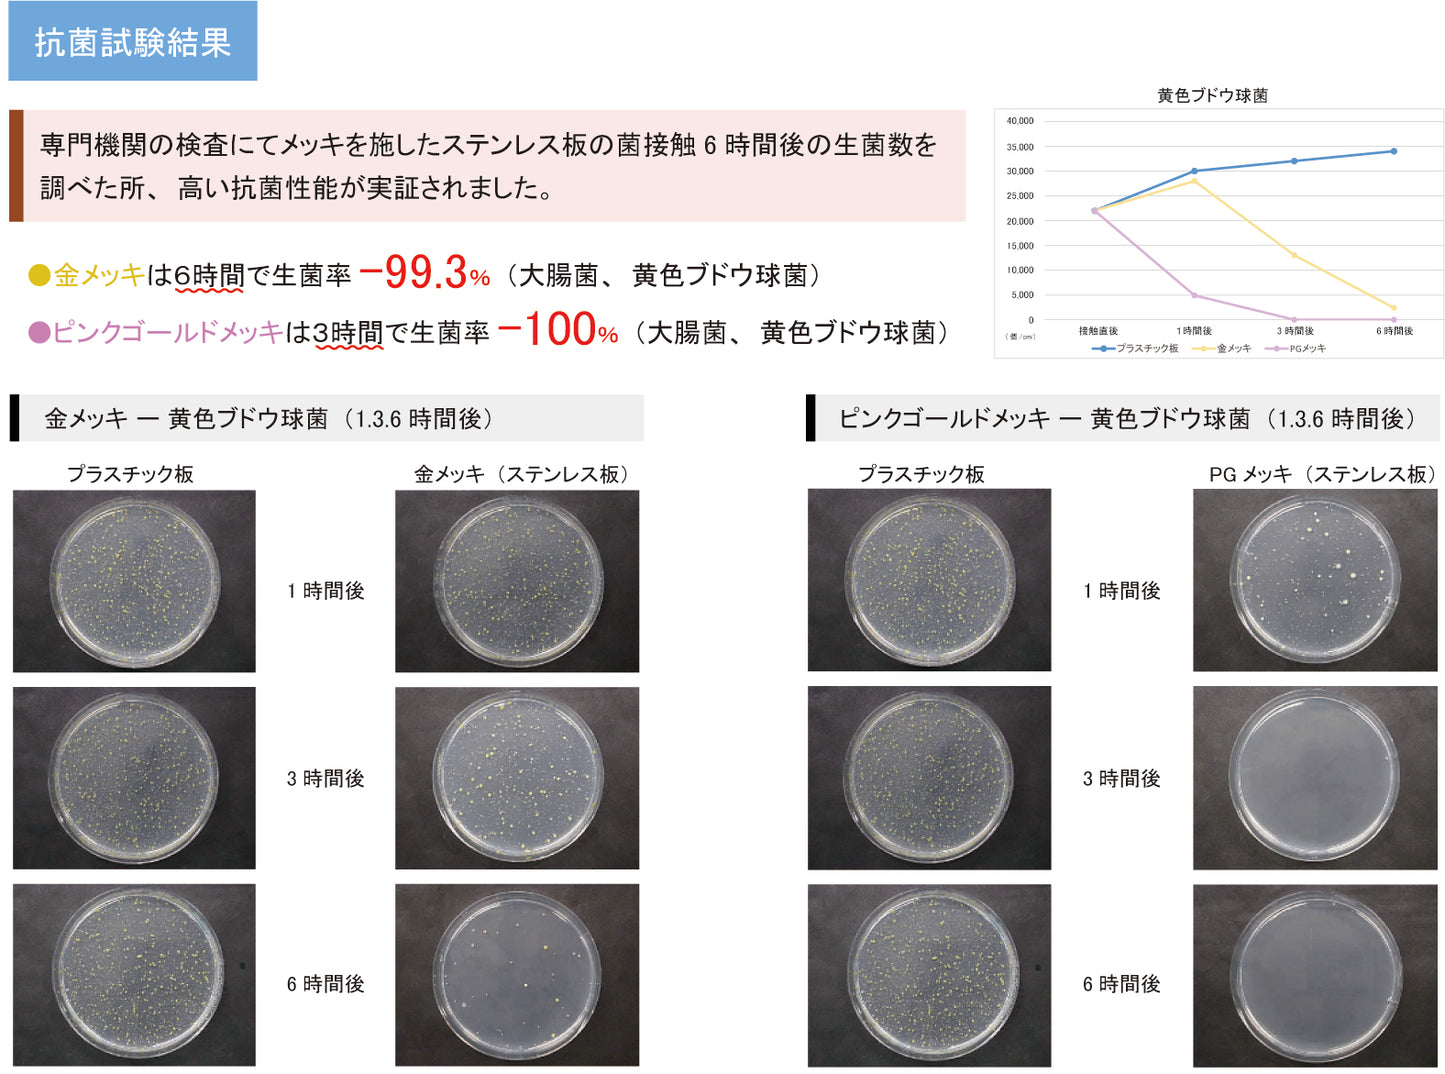
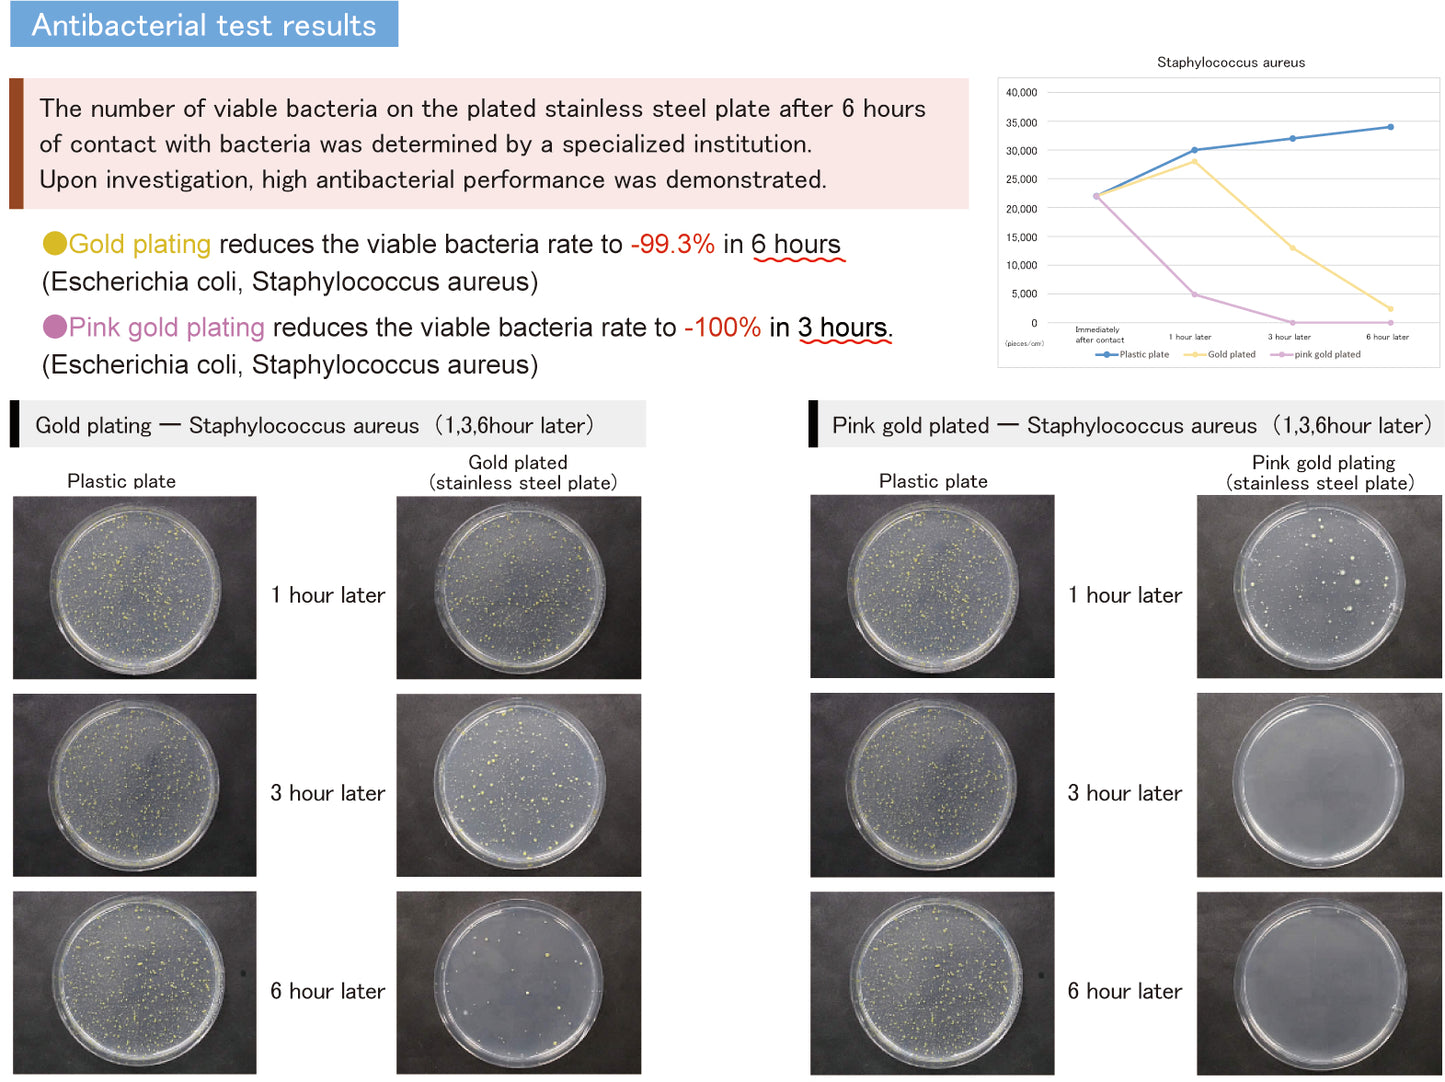

1
/
of
7
LCO0012G Bottle Opener (24K pure gold ion plated finish. The material of the product itself is CR-V.)
LCO0012G Bottle Opener (24K pure gold ion plated finish. The material of the product itself is CR-V.)
Regular price
¥5,500 JPY
Regular price
Sale price
¥5,500 JPY
Unit price
/
per
Tax included.
Couldn't load pickup availability
A small combination spanner has become a bottle opener.
It can open 12mm bolts securely and is also useful for opening the pull tab of canned juice.
It comes in a presentation box, so it's perfect as a gift.
・24K IP coating (Product material: CR-V)
・Has antibacterial activity (tested on Escherichia coli and Staphylococcus aureus)
・Hot forging
Share